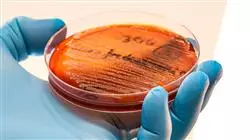
##IMAGE##

Universitäre Qualifikation
Die größte Fakultät für Pharmazie der Welt"
Präsentation
Erfahren Sie mehr über die modernsten Bakteriophagen-Therapien zur Bekämpfung von Krankheiten, die durch multiresistente Bakterien verursacht werden"

Jüngsten wissenschaftlichen Studien zufolge ist die Zahl der durch Antibiotikaresistenzen verursachten Todesfälle in den letzten Jahren angestiegen. Schätzungen zufolge könnte sie bis 2050 die häufigste Todesursache in der Welt sein. Dies hat die Gesundheitsbehörden veranlasst, ihre Bemühungen auf die Bekämpfung von Krankheiten, die durch multiresistente Bakterien verursacht werden, zu konzentrieren und modernste Therapien zu entwickeln, um sie wirksamer zu behandeln. Daher müssen Apotheker, die sich mit der Behandlung dieser Infektionen befassen, ein gründliches Verständnis dafür haben, um den neuen Herausforderungen im Gesundheitswesen gerecht zu werden.
Mit dieser Idee im Hinterkopf hat TECH beschlossen, dieses akademische Programm ins Leben zu rufen, das den Studenten ein intensives Update über Neue Strategien gegen Multiresistente Bakterien bieten wird. Durch diesen Abschluss werden die Herausforderungen des CRISPR-Cas9-Gen-Editierens sowie die Anforderungen und Grenzen der zeitlich begrenzten kollateralen Sensibilisierungsmethode analysiert. Ebenso werden Impfstoffe gegen die wichtigsten multiresistenten Bakterien, die derzeit entwickelt werden, oder moderne Antibiotika-Kombinationstherapien untersucht.
Dank des 100%igen Online-Modus, der in diesem Programm verwendet wird, können Pharmazeuten ihre berufliche Weiterbildung absolvieren, ohne täglich unbequeme Reisen zu einem Studienzentrum unternehmen zu müssen. Die Lerninhalte stehen 24 Stunden am Tag und in einer Vielzahl von Lernformaten wie Vorlesungen, Videos oder interaktiven Zusammenfassungen zur Verfügung. Auf diese Weise kann zu jeder Zeit gelernt werden, was die Effektivität des Lernens erhöht und den langfristigen Wissenserwerb sichert.
Greifen Sie von jedem beliebigen Ort und von jedem elektronischen Gerät aus auf Ihre Lerninhalte zu, um Ihr Lernen zu optimieren"
Dieser Universitätskurs in Neue Strategien gegen Multiresistente Bakterien enthält das vollständigste und aktuellste wissenschaftliche Programm auf dem Markt. Die wichtigsten Merkmale sind:
- Entwicklung von Fallstudien, die von Experten für Mikrobiologie, Medizin und Parasitologie vorgestellt werden
- Der anschauliche, schematische und äußerst praxisnahe Inhalt vermittelt alle für die berufliche Praxis unverzichtbaren wissenschaftlichen und praktischen Informationen
- Die praktischen Übungen, bei denen der Selbstbewertungsprozess zur Verbesserung des Lernens durchgeführt werden kann
- Sein besonderer Schwerpunkt liegt auf innovativen Methoden
- Theoretische Lektionen, Fragen an den Experten, Diskussionsforen zu kontroversen Themen und individuelle Reflexionsarbeit
- Die Verfügbarkeit des Zugangs zu Inhalten von jedem festen oder tragbaren Gerät mit Internetanschluss
Identifizieren Sie die aktuellsten Antibiotika-Kombinationstherapien zur Bekämpfung von Krankheiten, die durch multiresistente Bakterien verursacht werden"
Das Dozententeam des Programms besteht aus Experten des Sektors, die ihre Berufserfahrung in diese Fortbildung einbringen, sowie aus renommierten Fachkräften von führenden Gesellschaften und angesehenen Universitäten.
Die multimedialen Inhalte, die mit der neuesten Bildungstechnologie entwickelt wurden, werden der Fachkraft ein situiertes und kontextbezogenes Lernen ermöglichen, d. h. eine simulierte Umgebung, die eine immersive Fortbildung bietet, die auf die Ausführung von realen Situationen ausgerichtet ist.
Das Konzept dieses Programms konzentriert sich auf problemorientiertes Lernen, bei dem die Fachkraft versuchen muss, die verschiedenen Situationen aus der beruflichen Praxis zu lösen, die während des gesamten Studiengangs gestellt werden. Zu diesem Zweck wird sie von einem innovativen interaktiven Videosystem unterstützt, das von renommierten Experten entwickelt wurde.
Dank dieses Programms können Sie den Stand der Entwicklung von Impfstoffen gegen die wichtigsten multiresistenten Bakterien feststellen"

Möchten Sie über Neue Strategien gegen Multiresistente Bakterien auf dem Laufenden bleiben, ohne Ihr Haus zu verlassen? Holen Sie es sich mit diesem Programm"
Lehrplan
Der Lehrplan dieses Programms wurde mit der Absicht entwickelt, Pharmazeuten auf dem Gebiet der neuen Strategien gegen multiresistente Bakterien auf den neuesten Stand zu bringen, und zwar in einem 100%igen Online-Modus und ohne physische Reisen zu Studienzentren. So werden in den 6 Wochen, in denen man lernt, die Veränderung von Krankheitserregern untersucht, die eine wirksamere Behandlung von Infektionskrankheiten ermöglicht. Außerdem erhält man ein umfassendes Verständnis der Herausforderungen bei der Entwicklung von antibakteriellen Impfstoffen.
Durch diesen Abschluss werden die Herausforderungen bei der Entwicklung von antibakteriellen Impfstoffen vertieft"
Modul 1. Neue Strategien gegen multiresistente Bakterien
1.1. CRISPR-Cas9-Genbearbeitung
1.1.1. Molekularer Wirkmechanismus
1.1.2. Anwendungen
1.1.3. Beschränkungen und Herausforderungen
1.1.2.1. CRISPR-Cas9 als therapeutisches Mittel
1.1.2.2. Entwicklung von probiotischen Bakterien
1.1.2.3. Schneller Nachweis von Resistenzen
1.1.2.4. Entfernung von Resistenzplasmiden
1.1.2.5. Entwicklung neuer Antibiotika
1.1.2.6. Sicherheit und Stabilität
1.2. Vorübergehende kollaterale Sensibilisierung (SCT)
1.2.1. Molekularer Mechanismus
1.2.2. Vorteile und Anwendungen von SCT
1.2.3. Beschränkungen und Herausforderungen
1.3. Gen-Stilllegung
1.3.1. Molekularer Mechanismus
1.3.2. RNA-Interferenz
1.3.3. Antisense-Oligonukleotide
1.3.4. Vorteile und Anwendungen der Gen-Stilllegung
1.3.5. Beschränkungen
1.4. Sequenzierung mit hohem Durchsatz
1.4.1. Schritte der Hochdurchsatz-Sequenzierung
1.4.2. Bioinformatik-Tools für den Kampf gegen multiresistente Bakterien
1.4.3. Herausforderungen
1.5. Nanopartikel
1.5.1. Wirkungsmechanismus gegen Bakterien
1.5.2. Klinische Anwendungen
1.5.3. Beschränkungen und Herausforderungen
1.6. Ingeniería de bacterias probióticas
1.6.1. Producción de moléculas antimicrobianas
1.6.2. Antagonismo bacteriano
1.6.3. Modulación del sistema inmunitario
1.6.4. Aplicaciones clínicas
1.6.5. Limitaciones y desafíos
1.6.4.1. Prevención de infecciones nosocomiales
1.6.4.2. Reducción de la incidencia de infecciones respiratorias
1.6.4.3. Terapia adjunta en el tratamiento de infecciones urinarias
1.6.4.4. Prevención de infecciones cutáneas resistentes
1.7. Antibakterielle Impfstoffe
1.7.1. Arten von Impfstoffen gegen bakterielle Krankheiten
1.7.2. In der Entwicklung befindliche Impfstoffe gegen die wichtigsten multiresistenten Bakterien
1.7.3. Herausforderungen und Überlegungen
1.8. Bakteriophagen
1.8.1. Wirkungsmechanismus
1.8.2. Lytischer Zyklus von Bakteriophagen
1.8.3. Lysogener Zyklus von Bakteriophagen
1.9. Phagen-Therapie
1.9.1. Isolierung und Transport von Bakteriophagen
1.9.2. Aufreinigung und Handhabung von Bakteriophagen im Labor
1.9.3. Phänotypische und genetische Charakterisierung von Bakteriophagen
1.9.4. Präklinische und klinische Versuche
1.9.5. Mitfühlender Einsatz von Phagen und Erfolgsgeschichten
1.10. Antibiotika-Kombinationstherapie
1.10.1. Wirkungsmechanismen
1.10.2. Wirksamkeit und Risiken
1.10.3. Herausforderungen und Beschränkungen
1.10.4. Kombinierte Antibiotika- und Phagentherapie

Ein einzigartiges, wichtiges und entscheidendes Fortbildungserlebnis zur Förderung Ihrer beruflichen Entwicklung"
Universitätskurs in Neue Strategien gegen Multiresistente Bakterien
Entdecken Sie an der TECH Technologischen Universität den Universitätskurs in Neue Strategien gegen Multiresistente Bakterien, eine außergewöhnliche Gelegenheit, die neuesten Innovationen im Bereich der Pharmazie und Mikrobiologie zu erforschen und zu beherrschen. Dieses akademische Online-Programm richtet sich an Fachleute aus der Industrie und an Studenten, die sich eingehender mit dem Studium und der Anwendung wirksamer Strategien gegen antimikrobielle Resistenzen bei multiresistenten Bakterien beschäftigen möchten. Heutzutage haben Bakterien die Fähigkeit entwickelt, gegen mehrere Antibiotikabehandlungen resistent zu sein, was die Behandlung von Infektionskrankheiten sowohl in der Klinik als auch in der Lebensmittelproduktion erschwert. Der Kurs bietet einen umfassenden Rahmen, um zu verstehen, wie diese Krankheitserreger entstehen, sich verbreiten und die öffentliche Gesundheit beeinträchtigen. In interaktivem Online-Unterricht lernen die Teilnehmer alles von der Grundlagenforschung bis hin zu praktischen Anwendungen auf dem Gebiet. Es werden fortschrittliche Diagnosemethoden, neue antimikrobielle Therapien und gesundheitspolitische Maßnahmen zur Kontrolle und Verhinderung der Ausbreitung multiresistenter Bakterien erörtert.
Studieren Sie einen Online-Kurs und informieren Sie sich über multiresistente Bakterien
Die TECH Technologische Universität hat es sich zur Aufgabe gemacht, eine hochmoderne Weiterbildung anzubieten, die Theorie mit praktischen Anwendungen verbindet und die Studenten darauf vorbereitet, aktuelle und zukünftige Herausforderungen in der Mikrobiologie und Pharmazie zu meistern. Die Kursteilnehmer erwerben nicht nur Fachwissen, sondern auch kritische Fähigkeiten in den Bereichen Forschung, Datenanalyse und fundierte Entscheidungsfindung auf dem Gebiet der öffentlichen Gesundheit und Lebensmittelsicherheit. Nach Abschluss dieses Kurses werden Sie in der Lage sein, innovative Initiativen zu leiten und in multidisziplinären Teams zusammenzuarbeiten, um der wachsenden Bedrohung durch multiresistente Bakterien zu begegnen. Dieser Abschluss macht Sie zu einem Experten für neue Strategien gegen multiresistente Bakterien und trägt aktiv zur Förderung und zum Schutz der globalen Gesundheit bei. Machen Sie sich bereit, im Kampf gegen die antimikrobielle Resistenz einen bedeutenden Beitrag zu leisten. Schreiben Sie sich noch heute in den Universitätskurs der Fakultät für Pharmazie der TECH ein und weisen Sie den Weg in eine sicherere und gesündere Zukunft.







